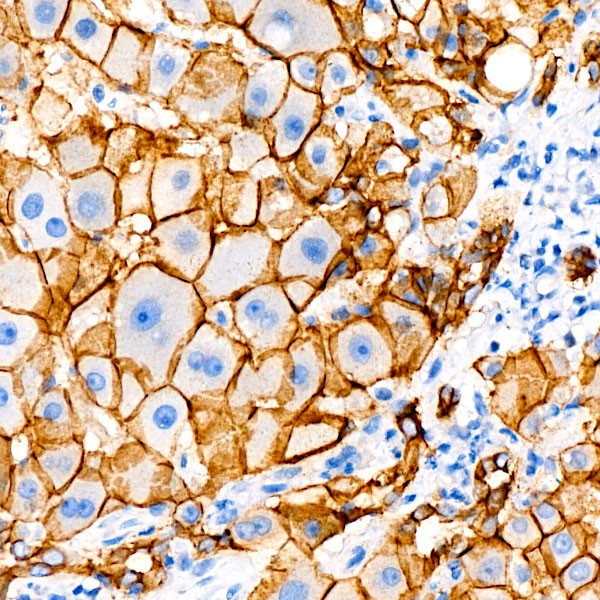
A22850: E-Cadherin Rabbit mAb
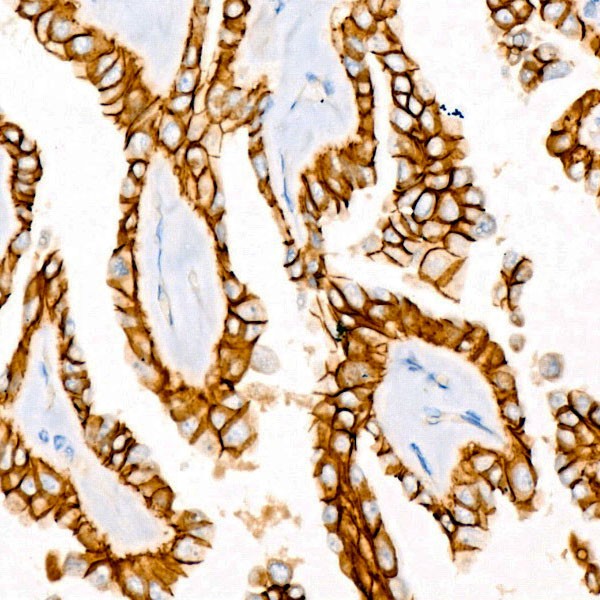
E-Cadherin Rabbit mAb (Catalog Number: A22850) Abclonal
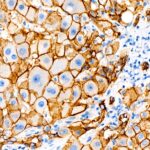

E-Cadherin Rabbit mAb (A22850)
$148.00 – $548.00
Abclonal E-Cadherin Rabbit mAb (Catalog Number: A22850) encodes a classical cadherin of the cadherin superfamily. Alternative splicing results in multiple transcript variants, at least one of which encodes a preproprotein that is proteolytically processed to generate the mature glycoprotein.
- Details & Specifications
- References
| Catalog No. | A22850 |
|---|---|
| Product Name | E-Cadherin Rabbit mAb (A22850) |
| Supplier Name | ABclonal, Inc. |
| Brand Name | Abclonal |
| Synonyms | UVO; CDHE; ECAD; LCAM; Arc-1; BCDS1; CD324 |
| Gene Name | CDH1 |
| Protein Name | CDH1 |
| Uniprot/Swissprot ID | P12830 |
| Gene ID | 999 |
| Clone | ARC57093 |
| Clonality | Monoclonal |
| Source/Host | Rabbit |
| Reactivity | Human, Mouse |
| Conjugate | Unconjugated |
| Note | Products will be shipped from the warehouse in Massachusetts. Promotion is running from time to time. Welcome to send a request for quote to message@sydlabs.com. |
| Order Offline | Syd Labs, Inc. 4 Avenue E, Hopkinton, MA 01748 USA. Phone: 1-617-401-8149 Fax: 1-617-606-5019 Email: message@sydlabs.com |
Description
A22850: E-Cadherin Rabbit mAb
This gene encodes a classical cadherin of the cadherin superfamily. Alternative splicing results in multiple transcript variants, at least one of which encodes a preproprotein that is proteolytically processed to generate the mature glycoprotein. This calcium-dependent cell-cell adhesion protein is comprised of five extracellular cadherin repeats, a transmembrane region and a highly conserved cytoplasmic tail. Mutations in this gene are correlated with gastric, breast, colorectal, thyroid and ovarian cancer. Loss of function of this gene is thought to contribute to cancer progression by increasing proliferation, invasion, and/or metastasis. The ectodomain of this protein mediates bacterial adhesion to mammalian cells and the cytoplasmic domain is required for internalization. This gene is present in a gene cluster with other members of the cadherin family on chromosome 16.
Immunogen Information about E-Cadherin Rabbit mAb (A22850)
Immunogen:Recombinant funsion protein containing a sequence corresponding to amino acids 155-707 of human E-Cadherin (NP_004351.1).
Sequence: DWVIPPISCPENEKGPFPKNLVQIKSNKDKEGKVFYSITGQGADTPPVGVFIIERETGWLKVTEPLDRERIATYTLFSHAVSSNGNAVEDPMEILITVTDQNDNKPEFTQEVFKGSVMEGALPGTSVMEVTATDADDDVNTYNAAIAYTILSQDPELPDKNMFTINRNTGVISVVTTGLDRESFPTYTLVVQAADLQGEGLSTTATAVITVTDTNDNPPIFNPTTYKGQVPENEANVVITTLKVTDADAPNTPAWEAVYTILNDDGGQFVVTTNPVNNDGILKTAKGLDFEAKQQYILHVAVTNVVPFEVSLTTSTATVTVDVLDVNEAPIFVPPEKRVEVSEDFGVGQEITSYTAQEPDTFMEQKITYRIWRDTANWLEINPDTGAISTRAELDREDFEHVKNSTYTALIIATDNGSPVATGTGTLLLILSDVNDNAPIPEPRTIFFCERNPKPQVINIIDADLPPNTSPFTAELTHGASANWTIQYNDPTQESIILKPKMALEVGDYKINLKLMDNQNKDQVTTLEVSVCDCEGAAGVCRKAQPVEAGLQI
Gene ID:999
Swiss prot:P12830
Synonyms:UVO; CDHE; ECAD; LCAM; Arc-1; BCDS1; CD324; E-Cadherin
Calculated MW:97kDa
Observed MW:135kDa
Images of E-Cadherin Rabbit mAb (A22850)

Western blot analysis of Mouse lung, using E-Cadherin antibody (A22850) at 1:1000 dilution.
Secondary antibody: HRP Goat Anti-Rabbit IgG (H+L) (AS014) at 1:10000 dilution.
Lysates/proteins: 25μg per lane.
Blocking buffer: 3% nonfat dry milk in TBST.
Detection: ECL Basic Kit (RM00020).
Exposure time: 180s.

Immunohistochemistry analysis of paraffin-embedded human liver using E-Cadherin Rabbit mAb (A22850) at dilution of 1:800 (40x lens).Perform high pressure antigen retrieval with 10 mM citrate buffer pH 6.0 before commencing with IHC staining protocol.

Immunohistochemistry analysis of paraffin-embedded human thyroid cancer using E-Cadherin Rabbit mAb (A22850) at dilution of 1:800 (40x lens).Perform high pressure antigen retrieval with 10 mM citrate buffer pH 6.0 before commencing with IHC staining protocol.

Confocal imaging of A-431 cells using E-Cadherin Rabbit mAb (A22850, at dilution of 1:200) (Green). The cells were counterstained with α-Tubulin Mouse mAb (AC012, dilution 1:400) (Red). DAPI was used for nuclear staining (blue). Objective: 100x.

Confocal imaging of MCF7 cells using E-Cadherin Rabbit mAb (A22850, at dilution of 1:200) (Green). The cells were counterstained with α-Tubulin Mouse mAb (AC012, dilution 1:400) (Red). DAPI was used for nuclear staining (blue). Objective: 100x.
Please remember our product information: E-Cadherin Rabbit mAb (Catalog Number: A22850) Abclonal